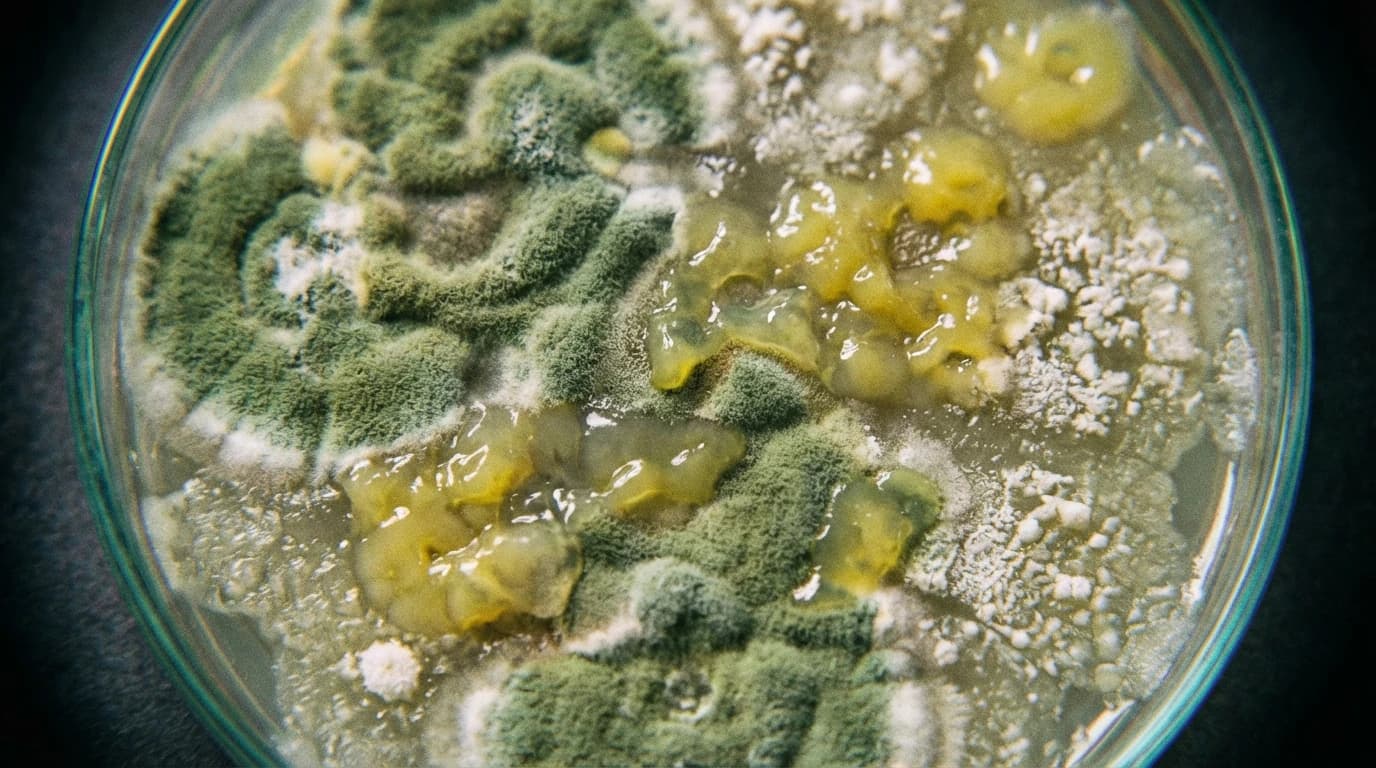
Image for Do Foundation Models Actually Improve Microbiome Disease Prediction?

A Clever Genetic White-Out Pen Could Rewrite Hutchinson-Gilford Progeria Syndrome
Researchers have developed a new base-editing tool called FATE that targets the fundamental mechanism behind rapid ageing in progeria cells. By acting like a precise genetic white-out pen, it stops toxic proteins from accumulating without disrupting the rest of the cell.